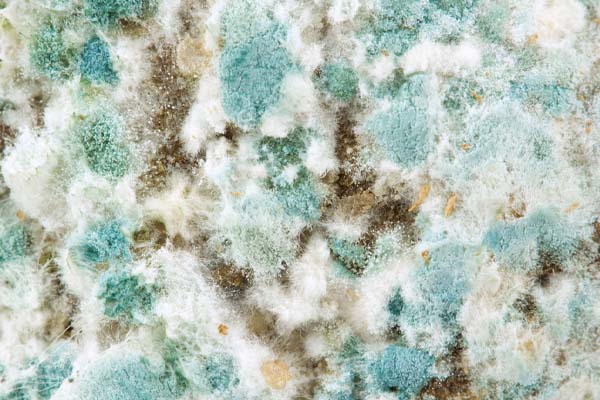

Kitchens must always be clean and fresh. After all, they are mainly used for food preparation. You wouldn’t want to cook or eat in a place that smells bad. Furthermore, you wouldn’t want to compromise your or your loved one’s health. If you have been diligently cleaning the space yet continue to notice a foul odor, then check the kitchen sink. This is the most likely source. When your kitchen sink drain smells bad, it could be a sign of an underlying issue that needs your immediate attention. Call a plumber for assistance if you want fast and reliable solutions.
Reasons Your Kitchen Sink Smells Bad
Contents
Below are some of the most common causes of foul kitchen sink drains:
1. Kitchen Sink Mold & Mildew
Water leaks are not always obvious. For example, the pipes under the sink may let water escape just a few droplets at a time. You may not notice the excess moisture since it doesn’t spill over to the kitchen floor. However, the water can penetrate the surrounding wood of the cabinetry. This can eventually encourage the growth of mold and mildew. You may not be able to see them but you can smell them in the air, especially when you are in front of the sink washing items. You can confirm this by looking under your sink for signs of leaks and water damage.
2. Grease in the Kitchen Drain
If you have eliminated the possibility of a leak, then explore other possible explanations. Perhaps cooking grease from plates and pans has created a clog in the pipes. This substance has the tendency to stick to the pipe walls and trap debris. Over time, the affected sections will get narrower until the path of the water gets completely blocked. Decomposing grease and debris will give off a foul smell that could waft back up to the kitchen sink. Homeowners can try to pour baking soda and vinegar into the drain to counter the grease. Wait for a few minutes before flushing everything down with hot water.
3. Dirty Garbage Disposal

Garbage disposal units are able to prevent clogs by shredding food scraps before they move down the pipes. Although this system is largely effective, bits of food can get stuck on the blades from time to time. Like all organic matter, this will rot and begin to smell. This is a common problem in homes with older garbage disposal units, particularly when these are used frequently. Failing to let the water run while grinding food scraps makes things worse. One quick remedy is to open the tap, turn on the disposal, and dump ice cubes into it. You can also add in salt, lemon rinds, or vinegar to help freshen up the blades.
4. Issue with the Kitchen Sink P-Trap

The P-trap is the curved piece of pipe under the sink. This is designed to hold water and prevent sewer fumes from getting into the house. If the sink smells like the sewers, then this might indicate that the water in the trap has somehow evaporated. This gives the sewer gas a clear path to the home. It could happen if you haven’t used the sink for a long time such as after a vacation. Just open the faucet and let the water run down to seal the trap. If nothing happens, then check for leaks. Call a plumbing company for further assistance.
5. Clogged Plumbing Vents
If the trap is clean and working fine, then you will have to check other possible sources of the sewer smell. You may be dealing with a clogged vent. This is a long vertical shaft that connects the sewer line to the outdoor air. Its presence is crucial in balancing the air pressure in the pipes. If this gets clogged, then water can move out of the trap, allowing foul gas to pass through. See if the plumbing vents are blocked by debris, nests, or other objects. There may also be a leak along the shaft that requires sealing.
6. Plumbing Errors
Consider the events leading to the development of the bad odors. Were there any changes that happened around the house? Was any work done on the main sewer line? Has the kitchen undergone major renovation recently? Did you get a plumbing issue fixed in the past few weeks? Perhaps there was a plumbing error during these projects that triggered the leaks or clogs. If so, then you should call the plumbers back so that they can make the corrections right away. They can inspect the whole system and identify the problem. They should fix their work free of charge. For those in the Lehigh Valley, call Robinson Plumbing. We can address all of your plumbing needs, the first time around. Your satisfaction is guaranteed.
Conclusion
Most homeowners will attempt to get rid of bad smells by themselves. There is nothing wrong with trying simple steps to freshen up the kitchen. If these don’t make a difference, then it is time to call the professionals. Look for plumbers who are known for their expertise and reliability. They will provide suitable solutions that last.
Call Robinson Plumbing For Superior Plumbing Services

Contact Robinson Plumbing, one of the most trusted plumbing companies in the Lehigh Valley, for reliable plumbing services. We offer various plumbing services ranging from drain clogs, water heater replacements, toilet repairs, water leaks, and more. We always give a wide range of solutions when possible for any plumbing repairs. This allows you to choose the best options for your home and budget.
Find yourself dealing with an unexpected plumbing problem in the middle of the night? No worries! You can count on the expert plumbers at Robinson Plumbing to take care of you. We offer reliable 24-hour emergency plumbing services. You can count on us to get the job done quickly and correctly and, best of all, at an affordable price.
We proudly offer the most affordable and best plumbing services in the Lehigh Valley area. Our plumbers all have the proper licenses and expertise to ensure your satisfaction. All of our work comes with a guarantee. Contact Robinson Plumbing today and schedule your free estimate.
Some of the areas we service include Allentown, Bethlehem, Easton, Lehigh Valley, Whitehall, and these zip codes: 1 8101, 18015, 18042, 18001, 18052, as well as all surrounding areas in the Lehigh Valley, Pennsylvania.
Call us today at (610) 351-9889 or contact us for any questions that you might have!
